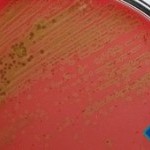
Cultura secreção pulmonar (escarro)
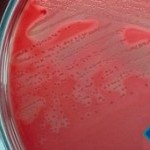
Cultura úlcera da perna
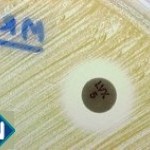
Zoom Antibiograma - 1

Caso nº 7
Caso Clínico #9
Local: Curitiba-PR
Mês / Ano: Junho/2001
Assuntos relacionados: Anemia Falciforme. Criança. Sexo Masculino.
Quadro Clínico
Menino com 12 anos de idade, negro, foi internado por febre, tosse, dor no peito e úlcera na perna. Estes sintomas começaram há sete dias. Por anos ele vem sendo tratado por úlceras recorrentes na perna. O seu irmão de 10 anos tem ataques de recorrência de febre e úlcera crônica nas pernas. Uma irmã faleceu de causa desconhecida. O pai, a irmã e mais quatro irmãos têm boa saúde e estão bem. No internamento foi solicitado hemograma, cultura e antibiograma de secreção pulmonar e úlcera de perna.
Com base nos dados clínicos e laboratoriais, propomos as seguintes questões para discussão do caso:
1. Como pode ser interpretada a cultura de secreção pulmonar?
2. Como deveria ser avaliada a amostra de secreção pulmonar a fim de que produzisse uma cultura significativa?
3. Qual o provável agente etiológico da infecção da úlcera de perna?
4. Qual a maneira correta de se coletar secreções de feridas e úlceras para exame bacteriológico?
5. Seria indicado fazer um esfregaço do material da úlcera para microscopia direta?
6. O antibiograma abaixo corresponde ao teste de suscetibilidade da bactéria isolada da úlcera de perna. Como deve ser interpretado?
7. Qual o tipo de mecanismo de resistência provavelmente apresentado por esta bactéria?
8. Qual o gene que codifica para este tipo de resistência e como pode ser pesquisado em laboratório que não dispõe de técnicas de Biologia Molecular?
9. Esta bactéria é exclusivamente hospitalar?
10. Qual mecanismo de defesa estava comprometido neste paciente facilitando o estabelecimento da infecção?
11. Classifique morfo e fisiologicamente esta anemia.
12. A morfologia eritrocitária pode ser associada com alguma doença?
13. Se o hemograma sugere alguma doença específica, ela é hereditária ou adquirida?
14. Que exames laboratoriais complementares ao hemograma devem ser realizados para se estabelecer um diagnóstico laboratorial?
15. Que interpretação deve ser feita do leucograma?
Referências Bibliográficas
1. SILVA, P. H. & HASHIMOTO, Y. Interpretação Laboratorial do Eritrograma. São Paulo, Ed. Lovise, 1999.
2. PILONETTO, M. & PILONETTO, D.V. Manual de procedimentos laboratoriais em Microbiologia. Curitiba, Ed. Microscience, 1998.
3. UNIVERSIDADE FEDERAL DO PARANÁ. Manual do Laboratório. Curitiba, Hospital de Clínicas, 1990.
4. MAHON, C.R. & MANUSELIS Jr., G. Textbook of Diagnostic Microbiology. Philadelphia, W.B. Saunders Company, 1995.
5. MILLER, J.M. A Guide to Specimen Management in Clinical Microbiology. Washington, ASM Press, 1996.
6. NATIONAL COMMITTEE FOR CLINICAL LABORATORY STANDARDS. Performance Standards for Antimicrobial Disk Susceptibility Tests. Approved standard M2-A7.Wayne, NCCLS, 2000.
7. KONEMAN, E.W. et al. Color Atlas and Textbook of Diagnostic Microbiology. 5th Ed. Philadelphia, Lippincott, 1997.
8. MURRAY, P.R. Manual of Clinical Microbiology. 7th Ed. Washington, ASM Press, 1999.
9. OPLUSTIL, C.P.; ZOCCOLI, C.M.; TOBOUTI, N.R.; SINTO, S.I. Procedimentos Básicos em Microbiologia Clínica. São Paulo, Sarvier, 2000.
10. SCHAETER, M.; MEDOFF, G.; EISENSTEIN, B.I.; GUERRA, H. Microbiologia: Mecanismos delas Enfermedades Infecciosas. 2da. Ed. Editorial Medica Panamericana, Madrid, 1994.
Dados Laboratoriais
Hemograma
Eritrócitos 1.400.000 / mL
Hemoglobina 4,0 g / dL
Volume globular 13,0 %
VCM 92,8 fL
HCM 28,6 pg
CHCM 30,0 %
RDW 19,8 %
Leucócitos 27.400 / mL
Mielócitos 0 %
Metamielócitos 0 %
Bastonetes 21 %
Segmentados 59 %
Eosinófilos 3 %
Linfócitos 17 %
Monócitos 3 %
Plaquetas 312.000 / mL
Observações:
Anisocitose +++
Pecilocitose +++
Policromatofilia +++
6% de eritroblastos ortocromáticos
Eliptócitos ++
Codócitos ++
Eliptócitos alongados e terminados em ponta ++
Respostas da discussão
1. Cultura pouco significativa, uma vez que se desconhece a qualidade da amostra. Desenvolvimento de colônias de diferentes espécies bacterianas, com predominância de estreptococos alfa-hemolíticos, característicos de microbiota de orofaringe.
2. A amostra de secreção pulmonar deveria ser avaliada através da coloração de Gram, quantificando leucócitos e células epiteliais por campo de 100x (objetiva panorâmica). Amostras com menos de 10 leucócitos e mais de 25 células epiteliais por campo não deveriam ser semeadas para cultura de germes comuns, uma vez que não são representativas de trato respiratório inferior.
3. Staphylococcus aureus oxacilina (meticilina) resistente (MRSA).
4. A superfície da úlcera ou ferida deve ser limpa com soro fisiológico estéril e o material coletado da base da lesão com seringa e agulha estéreis.
5. Sim, para verificar a quantidade de leucócitos e células epiteliais a fim de avaliar a qualidade da amostra antes de processá-la.
6. O microrganismo é resistente a vários antibióticos, inclusive a oxacilina, e deve ser considerado um S. aureus oxacilina (ou meticilina) resistente, MRSA.
7. Modificação de proteínas ligadoras de penicilina (PBPs), envolvidas na síntese da parede celular. A proteína modificada tem baixa afinidade a todos os beta-lactâmicos, tornando o microrganismo resistente a todas as penicilinas, às cefalosporinas, aos monobactâmicos e imipenêmicos.
8. Gene mecA, e pode ser pesquisado usando-se uma placa de ágar Muller Hinton contendo 6 mcg/mL de oxacilina, e fazendo semeadura da cepa-teste em forma de "spot". O crescimento de qualquer quantidade de colônias significa que a cepa é um MRSA.
9. Inicialmente, as cepas de MRSA eram predominantemente hospitalares, mas recentemente são encontradas tanto em amostras hospitalares quanto ambulatoriais.
10. A ruptura da barreira epitelial, devido às úlceras recorrentes na perna, que por sua vez advêm da oclusão de pequenos vasos e da conseqüente estagnação vascular no tecido subcutâneo, características de pacientes com anemia falciforme.
11. É uma anemia intensa (4,0 g/dL de Hb) normocítica e normocrômica (valores de VCM e HCM) com uma população heterogênea (valor do RDW) e com características de anemia hemolítica (policromatofilia +++ associada com 6% de eritroblastos). Se está, portanto, frente a uma anemia normocítica e normocrômica hemolítica.
12. A anisocitose intensa está de acordo com o valor do RDW. A pecilocitose também é intensa e reflete as alterações de codócitos, eliptócitos e eliptócitos terminados em ponta. O codócito está presente em anemias hemolíticas e fala a favor de hemoglobinopatias. Não poderia se pensar, neste caso, em talassemia porque a anemia não é microcítica e hipocrômica, o que é característico das talassemias. Hemoglobinopatia normocítica e normocrômica é compatível com hemoglobina S, hemoglobina C e associações de hemoglobinopatia S com outros tipos de hemoglobina ( b S-tal, a S-tal, SC entre outras ). A presença de eliptócitos terminados em ponta sugere o drepanócito, morfologia que deve ser confirmada pelo teste de falcização ou de solubilidade e pela eletroforese de hemoglobina.
13. Este hemograma sugere um quadro hematológico de anemia falciforme, a qual é uma doença hereditária autossômica recessiva
14. Teste de falcização vai indicar se há ou não a presença da hemoglobina S, ele não informa o genótipo do paciente nem se há associações com outros tipos de hemoglobina. A eletroforese de hemoglobina deve ser realizada para se caracterizar o genótipo (homozigoto- SS ou heterozigoto- AS ou, ainda, hemoglobina S em associação com outras hemoglobinopatias ). Sem se saber o resultado dos exames é de se pensar que este quadro seja compatível com anemia falciforme homozigota, devido a intensidade da anemia.teste de falcização resultou positivo e a eletroforese de hemoglobina mostrou uma única banda na posição S, confirmando o genótipo do paciente como sendo SS.paciente homozigoto, para a anemia falciforme, apresenta uma anemia hemolítica normocítica e normocrômica hemolítica, cuja hemólise é crônica e com episódios de crises de hemólise. A causa da anemia é o drepanócito, eritrócito rígido que causa vasooclusão.
15. Em episódios de hemólise intensa, como é este caso, o paciente pode apresentar leucocitose com neutrofilia e trombocitose, alterações devidas exclusivamente à hemólise. Neste caso existe um desvio nuclear à esquerda com leucocitose muito intensa. Este quadro fala a favor de um processo infeccioso. Pacientes com anemia falciforme estão sujeitos a infecções pulmonares e a úlceras de perna.